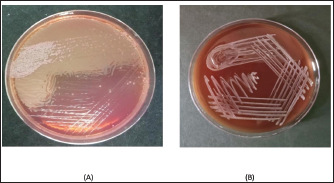

| Case Report | ||
J Microbiol Infect Dis. 2023; 13(3): 165-167 J. Microbiol. Infect. Dis., (2023), Vol. 13(3): 165–167 Case Report Burkholderia cepacia complex causing bacteremia in patients suffering from B-cell acute lymphocytic leukemia: A case reportMitra Kar*, Akanksha Dubey, Romya Singh, Chinmoy Sahu, Sangram Singh Patel and Nida FatimaSanjay Gandhi Postgraduate Institute of Medical Sciences, Department of Microbiology, Lucknow, India *Corresponding Author: Mitra Kar. Sanjay Gandhi Postgraduate Institute of Medical Sciences, Department of Microbiology, Lucknow, India. Email: mitrakar25 [at] gmail.com Submitted: 26/06/2022 Accepted: 12/08/2023 Published: 30/09/2023 © 2023 Journal of Microbiology and Infectious Diseases
AbstractBackground: Burkholderia cepacia complex consists of 24 species of microorganisms that include B. cepacia, Burkholderia multivorans, Burkholderia cenocepacia, Burkholderia vietnamiensis, Burkholderia ambifaria, and many more. It is a ubiquitous microorganism found in the soil and aquatic milieu. The most common infections caused by these isolates include bacteremia, pneumonia, genital tract infections, and surgical wound infections. Their potential to cause nosocomial outbreaks inward of immunocompromised patients is well known. Case Description: In this case report, we describe two cases of community-acquired Burkholderia vietnamese bacteremia in patients suffering from B-cell acute lymphocytic leukemia and their antibiotic sensitivity pattern to guide the treatment of these individuals. Conclusion: The identification of rare opportunistic pathogens like B. vietnamese and adequate treatment in the pandemic-ridden era is the need of the hour due to a rise in immunocompromised conditions owing to the rigorous use of antimicrobials and steroids. Keywords: Burkholderia cepacia complex (BCC), Hematological malignancy, Septicemia, Bacteremia, Burkholderia vietnamese. IntroductionBurkholderia cepacia is a pathogenic Gram-negative, aerobic Bacillus usually isolated from the aquatic milieu. It is identified as Burkholderia cepacia complex (BCC), which consists of 24 species, of which the most commonly isolated are B. cepacia, Burkholderia multivorans, Burkholderia cenocepacia, Burkholderia vietnamiensis, Burkholderia ambifaria, Burkholderia anthina, Burkholderia pyrrocinia, Burkholderia ubonensis, Burkholderia dolosa, and Burkholderia stabilis (Gautam et al., 2011; Bach et al., 2017). Bacteria belonging to the BCC group have recently emerged as the cause of opportunistic infections in immunocompromised individuals. The number of immunosuppressed individuals has increased in the wake of elderly debilitated patients, chronic kidney disease patients, cancer patients on chemotherapy, organ transplant patients, cystic fibrosis patients, and patients on immunosuppressant therapy, COVID-19 infections (Reik et al., 2005; Kalish et al., 2006; Coutinho et al., 2011). Immunosuppression in the case of cancer patients undergoing chemotherapy may either be due to the nature of the disease or it may be caused by the treatment (Mihaila and Blaga, 2013). Several studies have reported the isolation of the opportunistic pathogen as an outbreak-causing agent while admitted to the wards due to contamination of drugs and intravenous fluids (Singhal et al., 2015). In this case report, we describe two cases of community-acquired Burkholderia vietnamese bacteremia in young patients of B-cell acute lymphocytic leukemia, who were admitted to a 1,600 bedded teaching hospital in Northern India. Case DetailsCase 1A 29-year-old female presented to the internal medicine outpatient department with chief complaints of fever with chills and rigors, cough, and chest pain for the past 15 days. Her routine blood investigations were performed to reveal pancytopenia. She was referred to the hematology outpatient department where her bone marrow examination was evaluated to determine the cause of pancytopenia. Bone marrow was suggestive of almost complete replacement by small and medium-sized blast cells. The blast cells were myeloperoxidase negative. B-cell lineage was identified by flow cytometry and she was diagnosed with B-cell type acute lymphocytic leukemia. The patient continued to have persistent fever and pleuritic chest pain, for which he underwent high-resolution chest tomography on which nodular opacities were observed suggestive of fungal pneumonia for which liposomal amphotericin B was started. She became afebrile for 2 days but started to develop fever again. A blood culture sample was sent to the bacteriology section of the Department of Microbiology. The blood culture bottle came positive within 48 hours and on subculture on blood agar showed nonfermenting colonies (Fig. 1) which were identified as B. vietnamese by MALDI-TOF-MS assay. Antibiotic sensitivity testing was performed for the same by the Kirby Bauer disc diffusion method and was found sensitive to imipenem and meropenem. Treatment was started following the antibiotic sensitivity testing and her fever started responding after 7 days of starting antifungals and antibiotics. She was started on dasatinib and dexamethasone and tolerated this therapy well with no fever spikes or severe cytopenia. As her total leukocyte count was below 10,000/μl she was started on dasatinib 50 mg OD which was not increased further due to known interaction with antifungal voriconazole. Her family was counseled for her need for a bone marrow transplant. On discharge, she was advised to follow-up in the hematology outpatient department. Case 2A 22-year-old man presented to the internal medicine outpatient department with chief complaints of generalized weakness and pain in the upper limb for the past 15 days. He was advised for routine blood investigation which revealed cytopenia and was referred to the hematology outpatient department where his bone marrow examination revealed B-cell acute lymphoblastic leukemia. The patient came for a follow-up to the outpatient department within 15 days with high-grade fever and vomiting. On evaluation, he was found to have a non-neutropenic fever. His chest X-ray was normal. His blood sample was sent for procalcitonin assay and a pair of BACTEC blood cultures was raised and sent to the Bacteriology Section of the Department of Microbiology. His procalcitonin was 36 and his BACTEC blood culture flagged positive after 48 hours of incubation. On subculture, Mackonkey agar revealed growth of nonlactose fermenting, and Gram-negative bacilli blood agar showed hemolytic colonies which were identified as B. vietnamese by MALDI-TOF-MS assay. On antibiotic sensitivity testing by Kirby–Bauer’s disc diffusion method, the isolate was found sensitive to meropenem and levofloxacin. The patient was started on meropenem–cilastin according to the antibiotic susceptibility and the patient started to respond to treatment. His fever and vomiting subsided after 48 hours of antibiotic administration. His procalcitonin dropped to two after the treatment. The intravenous antibiotics were continued for 10 days and the patient was further stated on Tab Wysolone 100 mg OD and folic acid 5 mg OD. He was discharged in stable condition and was advised to continue chemotherapy as per schedule.
Fig. 1. Mackonkey agar (A) shows nonlactose fermenting colonies and blood agar (B) shows nonhemolytic colonies. Ethical approvalThe study protocol was approved by the institutional Ethics Committee of Sanjay Gandhi Postgraduate Institute of Medical Sciences (Reference number 2020-100-EMP-EXP-16) DiscussionBCC consists of a species named B. vietnamese which was the causative microorganism, identified from the blood culture of two patients suffering from bacteremia and impending sepsis. Burkholderia species naturally occur in the environment, especially in the aquatic milieu (Gautam et al., 2011). It is an aerobic, Gram-negative Bacillus that was found responsible for causing an array of infections in immunocompromised patients (Bach et al., 2017). It was predominantly reported as a respiratory pathogen in cystic fibrosis patients by Ashour and El-Sharif (2009) but can also cause infections in immunosuppressed patients like those suffering from chronic granulomatous disease, hematological malignancies, and solid tumors. BCC can be the causative agent causing bacteremia, pneumonia, genital tract infections, and surgical wound infections (Vonberg and Gastmeier, 2007). Cases of BCC bacteremia were reported in immunocompromised patients in several cases but most were identified as an outbreak of nosocomial infections among patients admitted to a particular hospital. A study conducted by Singhal et al. (2015) reported an outbreak of bacteremia among cancer patients admitted to a tertiary care center due to an infected antiemetic solution. The identification of community-acquired BCC has rarely been reported but their existence in the soil and water where the microorganism is acted upon by a plethora of plant metabolites renders it intrinsically resistant to antipseudomonal penicillins, first and second-generation cephalosporins, and aminoglycosides (Gautam et al., 2011). The isolates identified by us in our cases were susceptible to carbapenem and fluoroquinolones, but in both cases, the patients were symptomatic before admission and the BACTEC blood culture from both readily recovered the isolate on subculture on blood and Mackonkey agar. Environmental, drug, and medicated fluid surveillance can identify the source of an outbreak for these rare opportunistic isolates in the hospital setting, as has been performed by Mihaila and Blaga (2013), Singhal et al. (2015), and Tavares et al. (2020). Due to the lack of environmental surveillance measures, we could not identify the source of infection and the mechanism of acquiring the infection but the study makes it clear that immunosuppressed individuals are susceptible to acquiring such rare infections from the community. The isolation of rare microorganisms such as B. vietnamese needs to be discussed more frequently to know and frame the appropriate treatment for them. ConclusionThe identification of rare opportunistic pathogens such as B. vietnamese and adequate treatment in the pandemic-ridden era is the need of the hour due to a rise in immunocompromised conditions owing to the rigorous use of antimicrobials and steroids. Its intrinsic resistance to first and second-generation cephalosporins and polymixin can cause a state of alarm during treatment via empirical antibiotics. Thus, the MALDI-TOF-MS assay can be of help in directing the appropriate therapy to the patients. AcknowledgmentsThe author thanks the contribution of Mr. Malay Ghar, Mr. Aman, Mr. Ramesh, and all other laboratory staff for providing technical and logistic support. Conflict of interestNo conflict of interest to declare. FundingThis research did not receive any specific grant from any funding agencies. Author contributionProtocol development: Mitra Kar, Chinmoy Sahu. Data collection: Akanksha Dubey, Romya Singh. Nida Fatima. Data analysis: Chinmoy Sahu, Sangram Singh Patel. Supervision: Chinmoy Sahu, Sangram Singh Patel. Writing—original draft: Mitra Kar. Writing—review and editing: Mitra Kar, Romya Singh, Akanksha Dubey, Chinmoy Sahu, Sangram Singh Patel, Nida Fatima. All authors read and approved the final version of the manuscript. ReferencesAshour, H.M. and El-Sharif, A. 2009. Species distribution and antimicrobial susceptibility of gram-negative aerobic bacteria in hospitalized cancer patients. J. Transl. Med. 7, 14. Bach, E., Sant’Anna, F.H., Magrich dos Passos, J.F., Balsanelli, E., de Baura, V.A., Pedrosa, F.D.O., de Souza, E.M. and Passaglia, L.M.P. 2017. Detection of misidentifications of species from the Burkholderia cepacia complex and description of a new member, the soil bacterium Burkholderia catarinensis sp. nov. Pathog. Dis. 75, 6. Coutinho, C.P., Dos Santos, S.C., Madeira, A., Mira, N.P., Moreira, A.S. and Sa-Correia, I. 2011. Long-term colonization of the cystic fibrosis lung by Burkholderia cepacia complex bacteria: epidemiology, clonal variation, and genome-wide expression alterations. Front. Cell. Infect. Microbiol. 1, 12. Gautam, V., Singhal, L. and Ray, P. 2011. Burkholderia cepacia complex: beyond Pseudomonas and Acinetobacter. Indan. J. Med. Microbiol. 29, 4–12. Kalish, L.A., Waltz, D.A., Dovey, M., Potter-Bynoe, G., McAdam, A.J., LiPuma, J.J., Gerard, C. and Goldmann, D. 2006. Impact of Burkholderia dolosa on lung function and survival in cystic fibrosis. Am. J. Respir. Crit. Care. Med. 173, 421–425. Mihaila, R.G. and Blaga, L. 2013. Burkholderia cepacia septicemia in a patient with acute myeloid leukemia in postchemotherapy bone marrow aplasia. Pak. J. Med. Sci. 29(5), 1275–1277. Reik, R., Spilker, T. and LiPuma, J.J. 2005. Distribution of Burkholderia cepacia complex species among isolates recovered from persons with or without cystic fibrosis. J. Clin. Microbiol. 43, 2926–2928. Singhal, T., Shah, S. and Naik, R. 2015. Outbreak of Burkholderia cepacia complex bacteremia in a chemotherapy day care unit due to intrinsic contamination of an antiemetic drug. Indian. J. Med. Microbiol. 33, 117–119. Tavares, M., Kozak, M., Balola, A. and Sá- Correia, I. 2020. Burkholderia cepacia complex bacteria: a feared contamination risk in waterbased pharmaceutical products. Clin. Microbiol. Rev. 33, e00139–e00119. Vonberg, R.P. and Gastmeier, P. 2007. Hospital-acquired infections related to contaminated substances. J. Hosp. Infect. 65, 15–23. | ||
| How to Cite this Article |
| Pubmed Style Kar M, Dubey A, Singh R, Sahu C, Patel SS, Fatima N. Burkholderia cepacia complex (BCC) causing bacteremia in patients suffering from B-cell acute lymphocytic leukemia: A case report. J Microbiol Infect Dis. 2023; 13(3): 165-167. doi:10.5455/JMID.2023.v13.i3.9 Web Style Kar M, Dubey A, Singh R, Sahu C, Patel SS, Fatima N. Burkholderia cepacia complex (BCC) causing bacteremia in patients suffering from B-cell acute lymphocytic leukemia: A case report. https://www.jmidonline.org/?mno=302657421 [Access: January 25, 2026]. doi:10.5455/JMID.2023.v13.i3.9 AMA (American Medical Association) Style Kar M, Dubey A, Singh R, Sahu C, Patel SS, Fatima N. Burkholderia cepacia complex (BCC) causing bacteremia in patients suffering from B-cell acute lymphocytic leukemia: A case report. J Microbiol Infect Dis. 2023; 13(3): 165-167. doi:10.5455/JMID.2023.v13.i3.9 Vancouver/ICMJE Style Kar M, Dubey A, Singh R, Sahu C, Patel SS, Fatima N. Burkholderia cepacia complex (BCC) causing bacteremia in patients suffering from B-cell acute lymphocytic leukemia: A case report. J Microbiol Infect Dis. (2023), [cited January 25, 2026]; 13(3): 165-167. doi:10.5455/JMID.2023.v13.i3.9 Harvard Style Kar, M., Dubey, . A., Singh, . R., Sahu, . C., Patel, . S. S. & Fatima, . N. (2023) Burkholderia cepacia complex (BCC) causing bacteremia in patients suffering from B-cell acute lymphocytic leukemia: A case report. J Microbiol Infect Dis, 13 (3), 165-167. doi:10.5455/JMID.2023.v13.i3.9 Turabian Style Kar, Mitra, Akanksha Dubey, Romya Singh, Chinmoy Sahu, Sangram Singh Patel, and Nida Fatima. 2023. Burkholderia cepacia complex (BCC) causing bacteremia in patients suffering from B-cell acute lymphocytic leukemia: A case report. Journal of Microbiology and Infectious Diseases, 13 (3), 165-167. doi:10.5455/JMID.2023.v13.i3.9 Chicago Style Kar, Mitra, Akanksha Dubey, Romya Singh, Chinmoy Sahu, Sangram Singh Patel, and Nida Fatima. "Burkholderia cepacia complex (BCC) causing bacteremia in patients suffering from B-cell acute lymphocytic leukemia: A case report." Journal of Microbiology and Infectious Diseases 13 (2023), 165-167. doi:10.5455/JMID.2023.v13.i3.9 MLA (The Modern Language Association) Style Kar, Mitra, Akanksha Dubey, Romya Singh, Chinmoy Sahu, Sangram Singh Patel, and Nida Fatima. "Burkholderia cepacia complex (BCC) causing bacteremia in patients suffering from B-cell acute lymphocytic leukemia: A case report." Journal of Microbiology and Infectious Diseases 13.3 (2023), 165-167. Print. doi:10.5455/JMID.2023.v13.i3.9 APA (American Psychological Association) Style Kar, M., Dubey, . A., Singh, . R., Sahu, . C., Patel, . S. S. & Fatima, . N. (2023) Burkholderia cepacia complex (BCC) causing bacteremia in patients suffering from B-cell acute lymphocytic leukemia: A case report. Journal of Microbiology and Infectious Diseases, 13 (3), 165-167. doi:10.5455/JMID.2023.v13.i3.9 |